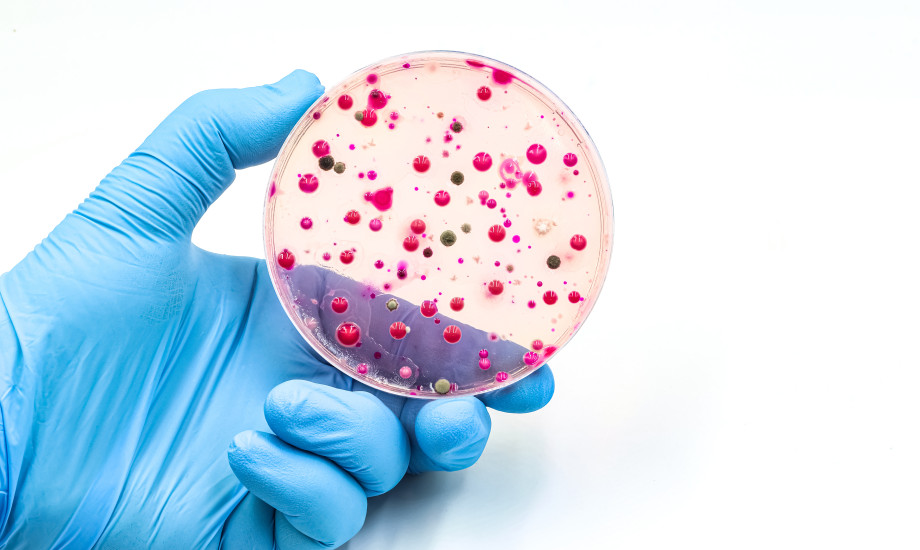

RKI veröffentlicht erstmals Resistenzdaten zu Pilzen
Auch bei Pilzen zeigen sich Resistenzentwicklungen, die überwacht und bei Therapieempfehlungen berücksichtigt werden müssen. Das Robert Koch-Institut (RKI) hat daher erstmals Daten zur Resistenzentwicklung bei Pilzen in Deutschland bis einschließlich 2024 veröffentlicht.
© TopMicrobialStock/stock.adobe.com
© TopMicrobialStock/stock.adobe.com 




Andrea Gaitanides_adobe_1481161567.jpg)


woravut_adobe_246321746.jpeg)






United States Department of Health and Human Services_888708448.png)



